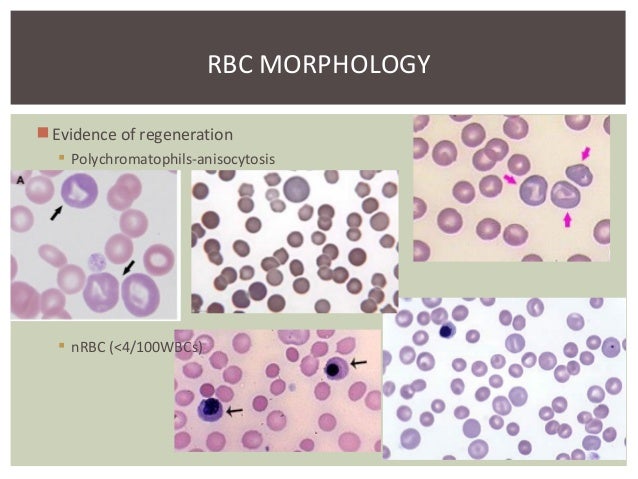

Feathered Edge Blood Smear

Practical Assessment Of Blood Smears In Dogs And Cats In Practice

Blood Smear Evaluation

Blood Smear Authorstream
Feathered Edge Blood Smear のギャラリー
Cvm Ncsu Edu Wp Content Uploads 16 09 Blood Smear Basics 16 Pdf

How To Get The Most From Blood Samples A Guide To Producing Diagnostic Blood Smears The Veterinary Nurse
Www Agric Wa Gov Au Sites Gateway Files Master your blood smear technique Pdf

Cytauxzoonosis

Peripheral Blood Smears Veterian Key

How Do I Make A Good Blood Smear Vetgirl Veterinary Ce Podcasts

Making A Great Blood Smear Sonopath

Platelet Estimates From Blood Smears In Dogs Clinician S Brief

1 General Assessment Veterian Key

5 Hematology Nurse Key

1 General Assessment Veterian Key
Http Williams Medicine Wisc Edu Blood Smear Pdf
Www Cshlpress Com Pdf Sample Mousehema4 Pdf
Www Marshfieldlabs Org Proxy Preparation Of Blood Smears 1 Pdf

1 General Assessment Veterian Key

Macroscopic Appearance Of Blood Films Medical Laboratories
Cvm Ncsu Edu Wp Content Uploads 16 09 Blood Smear Basics 16 Pdf
Q Tbn 3aand9gcrggsb5kbezhu3qn9x4kcoliht Zfh2q Ntx0hoktfeugzqqetg Usqp Cau

A Megakaryocyte In A Peripheral Blood Smear Springerlink

Blood Smear No Feathered Edge From Vetstream Definitive Veterinary Intelligence

Forest Huls Md Hemepath Chempath Case Challenge Feather Edge Of A Peripheral Blood Smear From A Pediatric Icu Patient Chart Says Ferritin 450 Ug L High Reference 25 350 Ug L Would You

Smear Examination Eclinpath
Http Williams Medicine Wisc Edu Blood Smear Pdf
Unusual Finding Of A Megakaryocyte In A Peripheral Blood Smear

In Clinic Hematology The Blood Film Review Today S Veterinary Practice
Http Phlebotomygeeks Yolasite Com Resources Geeks lab 10 blood smears Pdf
Cvm Ncsu Edu Wp Content Uploads 16 09 Blood Smear Basics 16 Pdf

How To Identify The Type Of Malaria On A Blood Smear Medmastery

Practical Challenges In Peripheral Blood Smear Evaluation Cap Today
Q Tbn 3aand9gcrupkzmxcqbtkvo1zut3ts7 C Cigmjwjgc Mfvwij5pzkzbp 8 Usqp Cau

Clinical Case Challenge What Can You Learn From A Peripheral Blood Smear News Center At Cummings School Of Veterinary Medicine At Tufts University
Gale Academic Onefile Document Retrospective And Prospective Investigations About Quatrefoil Erythrocytes In Canine Blood Smears
Www Jpc Capmed Mil Docs Veterinary Blood Smear Guide Pdf

Practical Challenges In Peripheral Blood Smear Evaluation Cap Today
Http Www Med Umich Edu Digitallab M2pathlabs Hemepath Pdf files Bockenstedt lab info Pdf

Feathered Edge Of Peripheral Blood Smear Medical Laboratories

Hematology Hemostasis College Of Veterinary Medicine At Msu
Q Tbn 3aand9gcrupkzmxcqbtkvo1zut3ts7 C Cigmjwjgc Mfvwij5pzkzbp 8 Usqp Cau

Solved Preparation Of A Blood Smear 41 A Properly Done B Chegg Com

Did You Know Platelet Clumping
Http Williams Medicine Wisc Edu Blood Smear Pdf

Blood Smear A Nada Al Juaid Ppt Video Online Download
Cvm Ncsu Edu Wp Content Uploads 16 09 Blood Smear Basics 16 Pdf

Preparation Of A Blood Smear Using The Concentration Line Technique Download Scientific Diagram

In Clinic Hematology The Blood Film Review Today S Veterinary Practice

Introduction To Peripheral Blood Smear Examination Oncohema Key

Carcinocythemia A Rare Entity Becoming More Common A 3 Year Single Institution Series Of Seven Cases And Literature Review Ronen 19 International Journal Of Laboratory Hematology Wiley Online Library

Blood Smear Platelet Evaluation Interpretation Clinician S Brief
Ieeexplore Ieee Org Iel7 Pdf
Cvm Ncsu Edu Wp Content Uploads 16 09 Blood Smear Basics 16 Pdf

How Do I Make A Good Blood Smear Vetgirl Veterinary Ce Podcasts
Lab4blood Smear Prep And Stain 08 Staining White Blood Cell

Blood Smear Platelet Evaluation Interpretation Clinician S Brief
.jpg.aspx)
Preparation Of Blood Smears Northern Light Health
Blood Smear Evaluation
Q Tbn 3aand9gcqeofm Xrgfbqs6ks9sbgdsmv Od6hg3rj2gs74zxd Uowal1ym Usqp Cau

How To Identify The Type Of Malaria On A Blood Smear Medmastery

Week Four Hematology Cbc Leukocytes Ppt Video Online Download

How To Read A Blood Smear Pathology Student

Peripheral Blood Smear Examination

Blood Smear Evaluation

Blood Smear Preparation Clinician S Brief

Feathered Edge Of A Blood Smear Eclinpath

Feather Archives Eclinpath

Micromegakaryocyte In A Patient With Myelofibrosis This Is A Very Thick Part Of The Smear In The Feather Edge Ther Myelofibrosis Hematology Clinical Research
2

1 General Assessment Veterian Key

Blood Film Wikipedia

Did You Know Platelet Clumping

Introduction To Peripheral Blood Smear Examination Oncohema Key

Forest Huls Md Hemepath Chempath Case Challenge Feather Edge Of A Peripheral Blood Smear From A Pediatric Icu Patient Chart Says Ferritin 450 Ug L High Reference 25 350 Ug L Would You

The Feather Edge Of A Peripheral Blood Smear From The Initial Blood Download Scientific Diagram

Blood The Good The Bad And The Ugly Microbiology A Laboratory Experience
Leukemia Cells Feather Edge

Hematology Hemostasis College Of Veterinary Medicine At Msu

Peripheral Blood Smears Feathered Edge Of Peripheral Blood Smear Medical Laboratories

Part One Deferential White Blood Cells Count Diff Wbcs Count And Microscopic Examination Of Well Stained Blood Film Page 2 Medicine Science And More

Few Qrbcs Seen Black Circle In The Feathered Edge Area Of The Blood Download Scientific Diagram

Figure 2 From What Is Your Diagnosis Blood Smear From A Cat Semantic Scholar
Hem Lab3 Blood Smears F10 Staining Histology

Figure 1 From Automatic Zone Identification In Blood Smear Images Using Optimal Set Of Features Semantic Scholar

Samples For Hematology Cornell University College Of Veterinary Medicine

Scopio Labs Receives Fda Clearance For Its Ai Powered Full Field Peripheral Blood Smear Full Field Pbs Application

Feathered Edge Of Peripheral Blood Smear Medical Laboratories

In Clinic Hematology The Blood Film Review Today S Veterinary Practice

Anatomy Of A Blood Smear Flashcards Quizlet
Http Williams Medicine Wisc Edu Blood Smear Pdf

Pin On Vet Stuff

Blood Smear And Cell Breakthrough The Gulls Of Appledore

The Criteria Of A Good Blood Film Medical Laboratories

Ppt Erythropoiesis Powerpoint Presentation Free Download Id

In Clinic Hematology The Blood Film Review Today S Veterinary Practice
Blood Smear 09 No Feathered Edge Illustration Cats Vetlexicon Felis From Vetstream Definitive Veterinary Intelligence

Blood Smear Preparation And Staining

Peripheral Blood Smears Feathered Edge Of Peripheral Blood Smear Medical Laboratories
Cvm Ncsu Edu Wp Content Uploads 16 09 Blood Smear Basics 16 Pdf

Blood Smear Features Eclinpath

Diagnostic Blood Smear Preparation Clinician S Brief

Peripheral Blood Smears Veterian Key

Clinical Case Challenge What Can You Learn From A Peripheral Blood Smear News Center At Cummings School Of Veterinary Medicine At Tufts University

In Clinic Hematology The Blood Film Review Today S Veterinary Practice